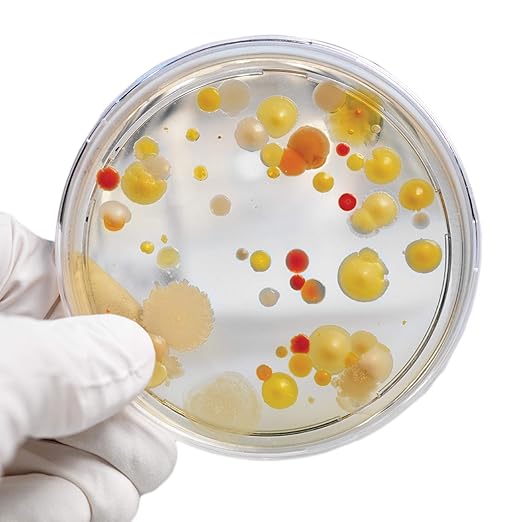
Steve Spangler's Growing Bacteria Science Experiment Kit

The positive impacts of science experiment kits and kids art activities on children are:
- Problem-Solving Skills: Both science experiments and art help children develop critical thinking and problem-solving abilities as they experiment and create.
- Creativity and Imagination: These activities encourage children to think creatively and use their imagination while exploring new ideas and techniques.
- Confidence and Sense of Accomplishment: Completing experiments and art projects gives children a sense of achievement, boosting their self-confidence and motivation.
These activities support children's cognitive, emotional, and social development.